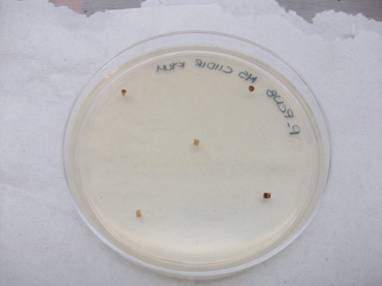

El proyecto busca emplear los aislados seleccionados en bioensayos como potenciales antagonistas a Fusarium verticillioides, para ser probados en invernadero, realizar una primera validación de los antagonistas, y desarrollar un paquete tecnológico
Fundación Produce Sinaloa, A.C., a través de su Consejo Consultivo zona norte, apoyará por cuarto año consecutivo el proyecto Obtención y evaluación de un banco de germoplasma de microorganismos nativos de Sinaloa asociados a maíz para desarrollar bioprotectores para el control de Fusarium, el cual tiene como finalidad en el ejercicio 2011-2012.
Seleccionar en invernadero los tres mejores aislados de un total de 15 seleccionados, así como la mejor combinación de estos tres con base en su compatibilidad y a su capacidad de inhibición de la severidad de Fusarium (70 %).
Caracterizar los distintos grupos genéticos de Fusarium (un máximo de 20 grupos), y estandarizar la metodología de propagación del inóculo bacteriano en fermentador de 2 litros para contar con suficiente inóculo para la prueba en campo.
Se llevará a cabo una primera prueba de validación colocada y evaluada en al menos tres parcelas en campo con una extensión máximo de 1 hectárea, para medir el efecto de la mejor mezcla o aislado en campo sobre la incidencia de fusariosis en maíz.
Se seleccionará el mejor tratamiento: aquel donde se obtenga la menor incidencia y severidad de la enfermedad por lote comparada con el control sin bacteria.
El proyecto busca alternativas biológicas que permitan controlar el desarrollo de Fusarium
El proyecto busca alternativas biológicas que permitan controlar el desarrollo de Fusarium
El maíz representa uno de los cultivos más importantes en Sinaloa y el que es cultivado en una mayor extensión, lo que aumenta el riesgo del surgimiento de alguna enfermedad que pueda resultar devastadora para este cultivo.
A partir del 2008 se ha presentado la fusariosis. Este problema es causado por Fusarium, un hongo que no es privativo de una zona de producción en particular, sino que se encuentra presente en todo el estado de Sinaloa.
La infección por Fusarium no es privativa de la cadena productiva maíz sino que son también un problema en la superficie que se emplea para el cultivo de hortalizas y otros granos.
El problema es que erradicar a un organismo tan resistente del suelo, como Fusarium, es muy difícil, y las técnicas como la solarización (técnica que consiste en cubrir el suelo húmedo con plástico transparente delgado durante el verano, a fin de incrementar las temperaturas para destruir a la mayoría de los fitopatógenos, insectos y malas hierbas) o la esterilización empleando químicos no son infalibles.
Un problema adicional en maíz, es que es uno de los cultivos hospederos de un número de microorganismos que pueden producir micotoxinas; entre estos está Fusarium verticilloides, el cual se aloja en el suelo y en el grano, y produce toxinas que afectan la salud humana y animal.
Esta problemática se plantea enfrentar con el presente proyecto en diferentes etapas. En este ejercicio, se plantea emplear los aislados seleccionados en bioensayos como potenciales antagonistas a Fusarium verticillioides, para ser probados en invernadero en el primer semestre del proyecto, y poder realizar una primera validación de los antagonistas, así como desarrollar un paquete tecnológico con base en los productos agrobiológicos desarrollados para el combate a la fusariosis del maíz.
Resultados del ejercicio 2010-2011
-
Se obtuvo un listado con las 14 mejores bacterias antagonistas a Fusarium evaluadas en semilla, seleccionadas con base en su nivel de inhibición a Fusarium en pruebas de laboratorio (mayor a 65 %) y en que no presentan hemólisis (desintegración de los glóbulos rojos) completa (tipo beta), la cual está relacionada con enfermedades humanas.
-
Se identificaron en pruebas estériles en maceta los tres mejores aislados bacterianos, pertenecientes a diferentes especies del género Bacillus (13, 23 y 35), que funcionan en planta para probar en maceta.
-
Se obtuvo la ubicación de doce lotes de maíz en cuatro municipios de Sinaloa que presentaron diferentes niveles de incidencia de fusariosis. Se seleccionaron los campos experimentales como los lugares óptimos para evaluar los antagonistas en campo. Y se considerarán lotes, de los que se muestrearon, que mostraron elevada incidencia, para realizar las pruebas de validación de los mejores antagonistas seleccionados en campo.
-
Se corroboró la identidad molecular del agente causal de fusariosis del maíz en 117 aislados de este hongo: además de haber ubicado 21 grupos genéticos diferentes, los cuales serán confirmados en cuanto a su agresividad a la planta de maíz en el siguiente ciclo. El mapeo de los lotes permitirá ubicar grupos genéticos y relacionarlos con su agresividad, con el fin de tomar decisiones para el manejo del cultivo y el control del patógeno.
Información proporcionada por Ignacio Eduardo Maldonado Mendoza, responsable del proyecto y perteneciente al Centro Interdisciplinario de Investigación para el Desarrollo Integral Regional (CIIDIR).

